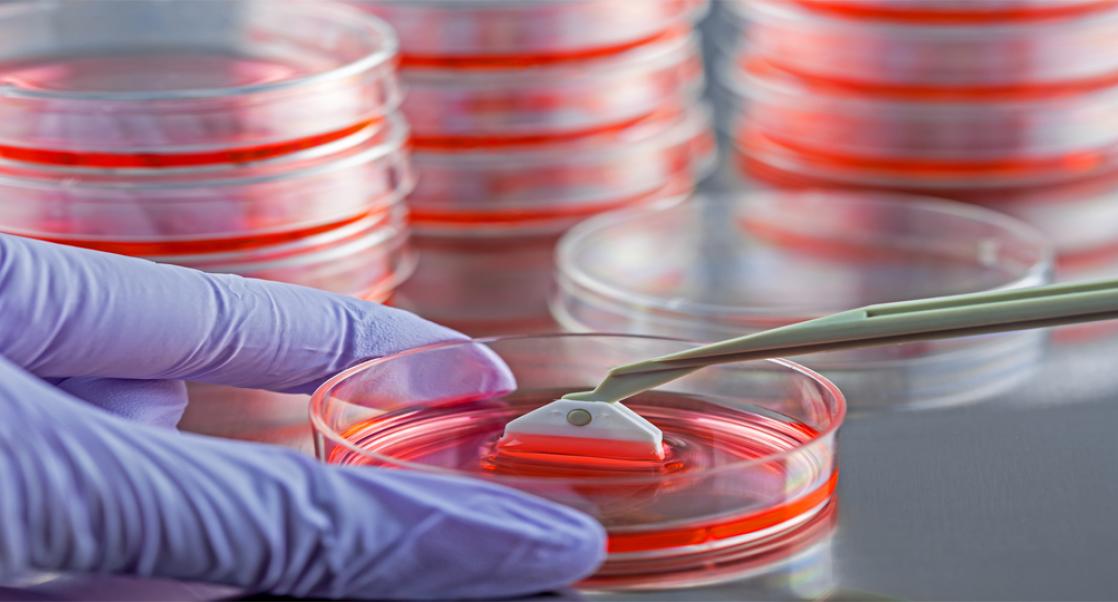
Altered States

Safety Assessment
|
Mary Parker
Current Trends in Toxicology (Video)
Like so many meetings, the American College of Toxicology meeting, which opens Nov. 12, is going virtual this year. Members will be gathering over four days, through their computers, iPhones and tablets to talk about the latest trends in toxicology and share their war stories. Invariably, the discussion will shift to COVID and its broad effect on how laboratories are functioning. Eureka gathered three of Charles River's tox experts, Shawna Jackman, PhD, Senior Principal Scientist and an expert in cellular therapies, Mike Templin, PhD, a Director of Scientific Advisory Services and Jeff Haskins, PhD, Executive Director of Global In Vitro Toxicology to chat about cell and gene therapy, predictive toxicology and IND-enabling studies and how their work has been colored by the pandemic.